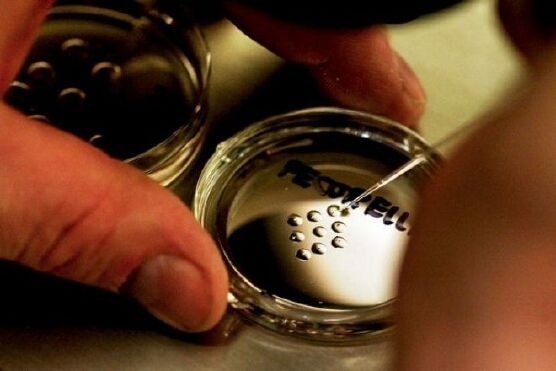
Phát hiện chấn động về 'trinh sản', giúp phụ nữ có thể sinh con không cần tinh trùng?

Nghe tiếng động lạ trên trần, người đàn ông bủn rủn khi thấy cảnh tượng trước mắt
Hoảng hồn phát hiện tổ ong bắp cày khổng lồ dài gần 1 mét treo trên trần nhà ở Quảng Tây.
Tìm theo từ khóa

Hoảng hồn phát hiện tổ ong bắp cày khổng lồ dài gần 1 mét treo trên trần nhà ở Quảng Tây.

Người dân khu vực không hề biết có tổ ong bắp cày tại địa điểm này.

Sự việc đau lòng khiến người cha vô cùng suy sụp.

Sự việc xảy ra với người đàn ông khiến dư luận xôn xao.

Chỉ khoảng 50 giây sau đó, con chuột đã nằm bất động trên mặt đất và con ong bay đi.
Có nhất thiết cần cả bố và mẹ mới có thể có em bé hay không? Đây vốn là câu hỏi lâu đời của khoa học. Với sự phát triển của khoa học kỹ thuật sinh học hiện nay, chúng ta đang tiến dần đến câu trả lời.